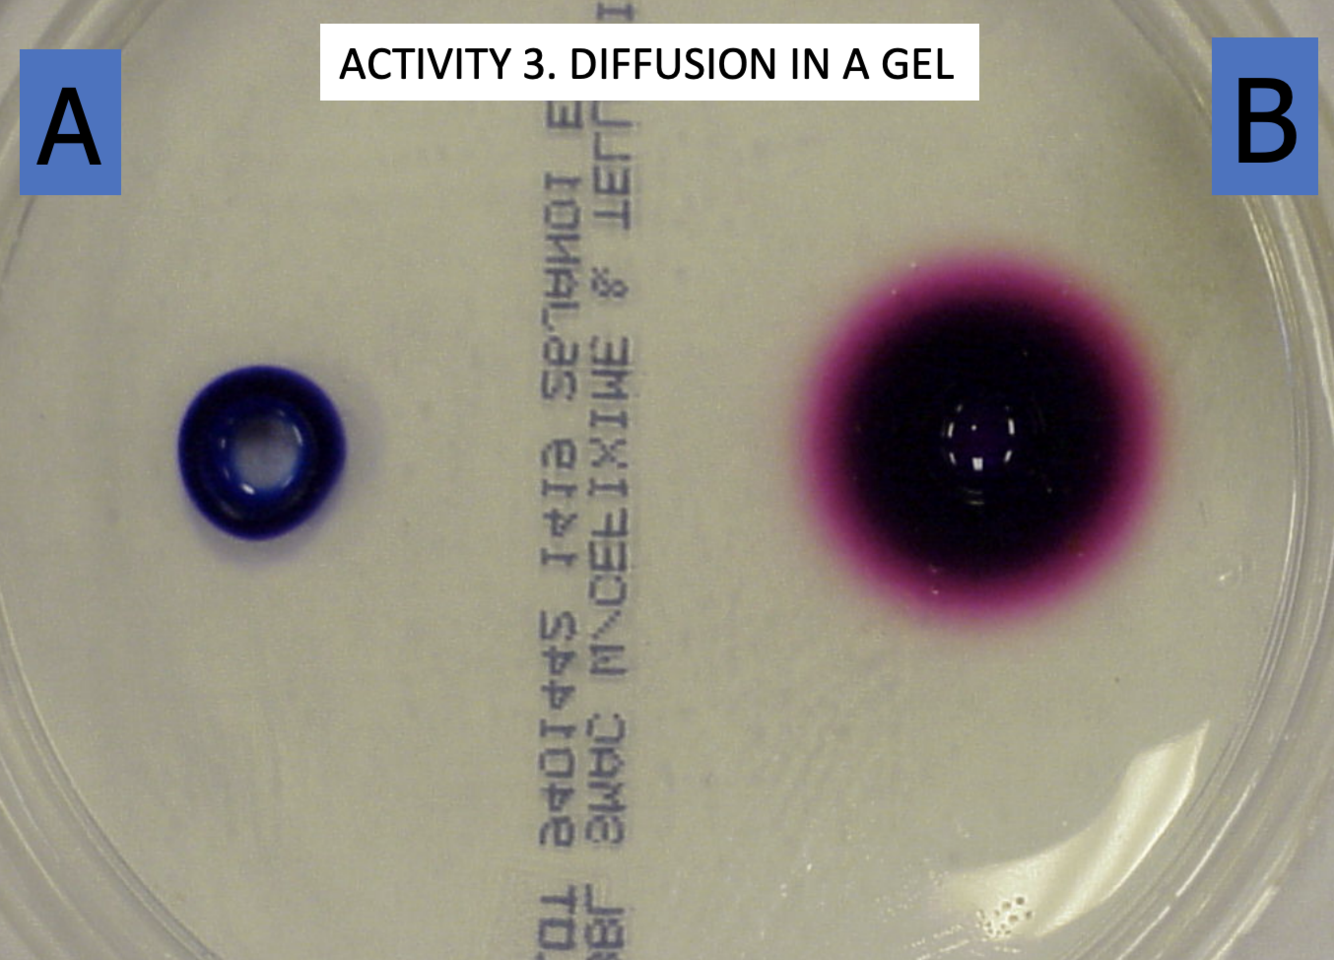

____: Holds focus when strength increases
Parfocal
____: The space between the objective lens and the slide
Working distance
When testing for starch, you use ____ as an indicator
Iodine
A translucent area on paper indcates the presence of ____
lipids
The protein test uses a ____ agent

Biuret
Ammonia has a pH of ____
11
Vinegar has a pH of ____
3
Why does water have a pH of 4
When distilled water is exposed to room air it absorbs CO2 which reacts with water to form carbonic acid which is acidic
Pure distilled water should have a pH of ____
7
____ minimize small changes in pH
Buffers
The ____ acid and ____ buffer systems in the human body act in the same way to balance blood pH.
carbonic; bicarbonate
____ is a measure of the rate of how fast molecules are moving.
Temperature
Which tube has a higher temperature

B
Gels are ____ in which their molecules swell up when they absorb water
colloids
Why did B diffuse faster than A
Beause of their molecular weight. B has a smaller molecular weight
Starch molecules remain inside the tubing because they are ____ to pass through the openings in the tubing wall.
too large
____ is the diffusion of water from an area of greater concentration to an area of lesser concentration
Osmosis
Water in the beaker is the ____ solution.

hypotonic
Syrup solution in the tubing represents a ____ solution

Hypertonic
____ molecules don’t leave the tubing because they are too large.

Syrup
____: A liquid or gas in which smaller amounts of other substances can be dissolved or suspended
Solvent
____: A solution containing more solute or lower water concentration than that of cells placed on it
Hypertonic solution
____: A solution containing less solute and more water than cells placed on it
Hypotonic Solution
What is this

Glycolysis